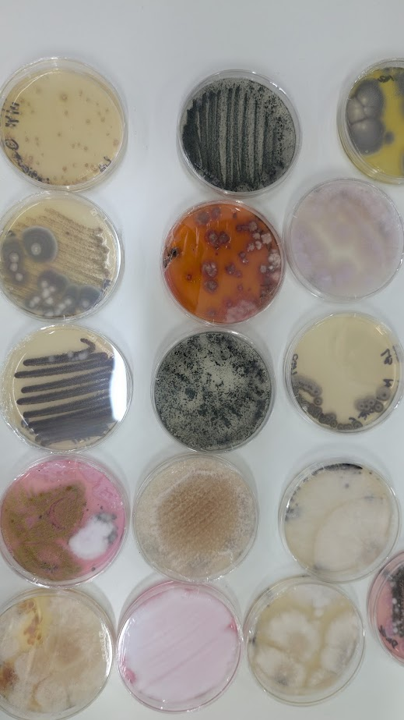
Gabriel Tinghitella tweet media

Sabitlenmiş Tweet

Lanzamos la Edición N° 12 de #CREALab, el programa de incubación de startups agtech de CREA
Accede a:
✅Formación y mentorías con expertos de 1er nivel
✅Networking con referentes del sector
✅Vinculación con la Red CREA
⏱️Límite: 31/3
📋Postulaciones👉bit.ly/CREAlab2026

Español